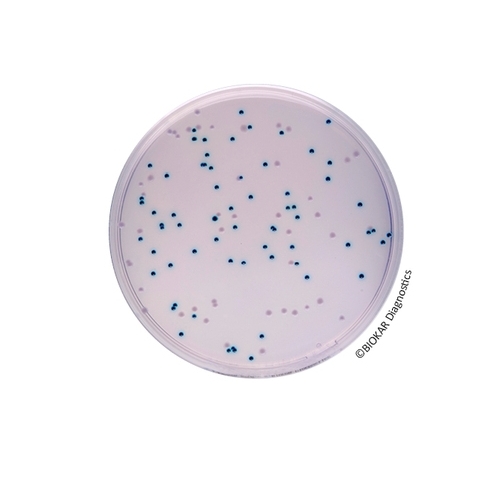
COMPASS® Enterobacter sakazakii Agar

The COMPASS® Enterobacter sakazakii Agar
The COMPASS® Enterobacter sakazakii Agar is used for the detection of Cronobacter sakazakii and spp. in milk powder, dehydrated products and their components found in infant foods.
| Ürün Adı | COMPASS® Enterobacter sakazakii Agar |
| Ürün Kodu | BM12008 |
| Miktar | 20 Petri plates Ø 90 mm |
| Ürün Adı | COMPASS® Enterobacter sakazakii Agar |
| Ürün Kodu | BK188HA |
| Miktar | 500 g |
TECHNICAL DATA SHEET
TDS_COMPASS ENTEROBACTER SAKAZAKII AGAR_BK188_BM120_ENv4
MSDS
Non classification statement_BM120